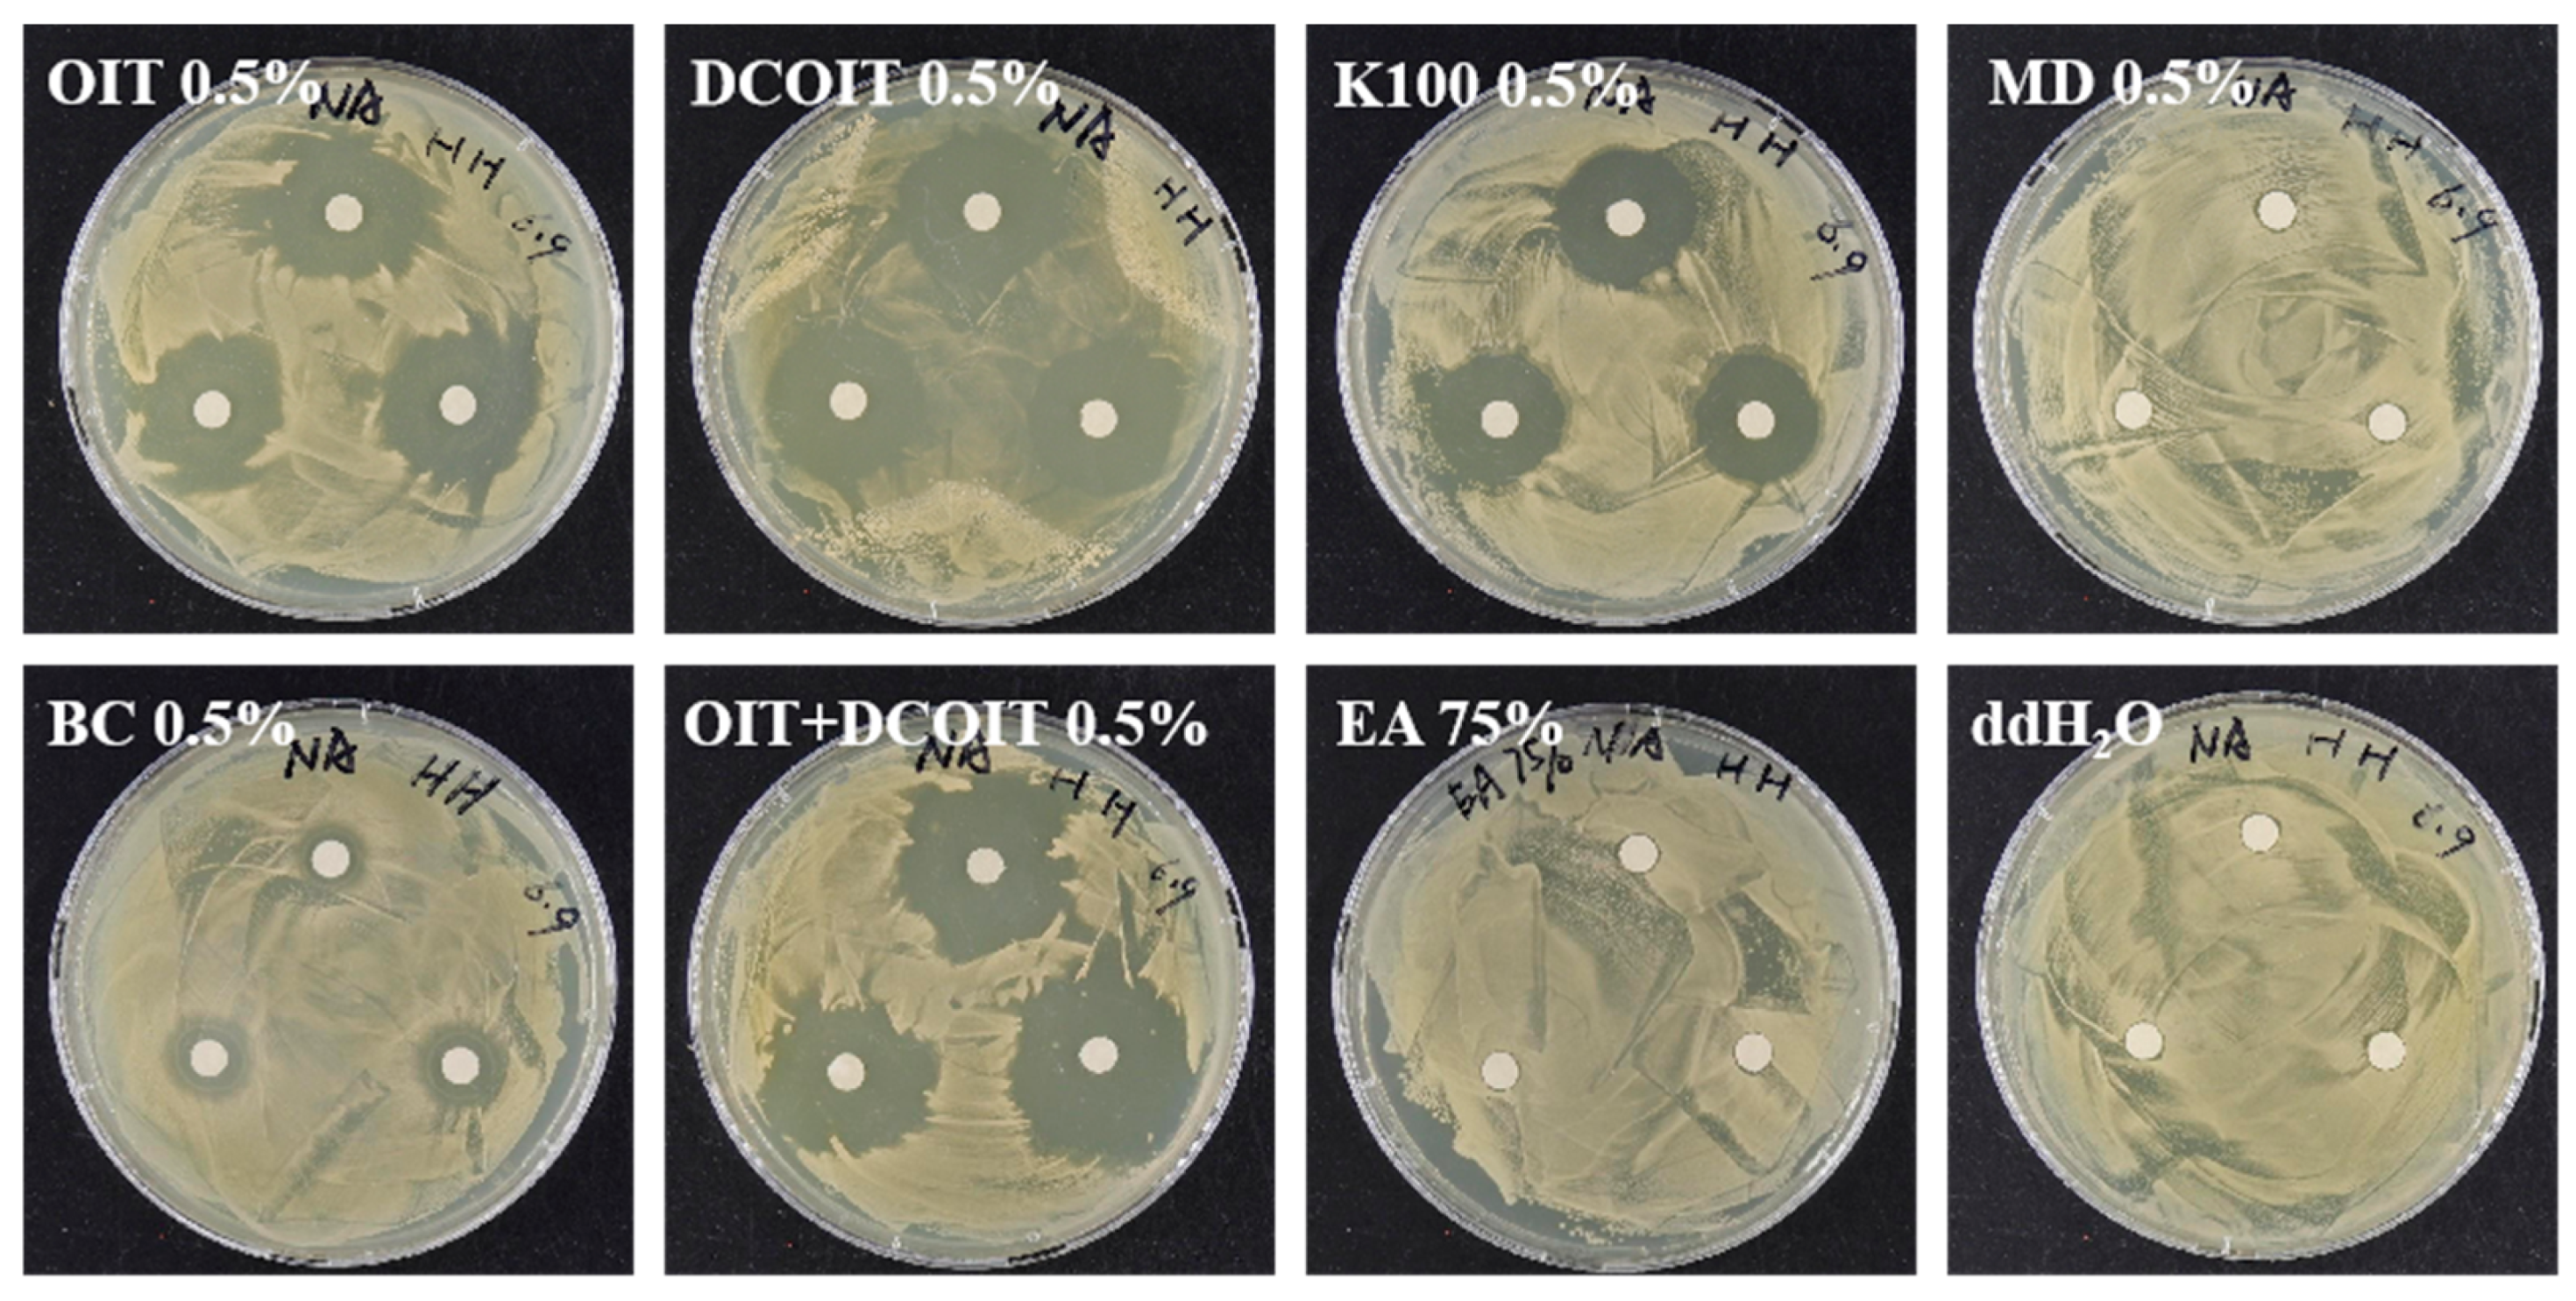
Coatings 14 00100 g010
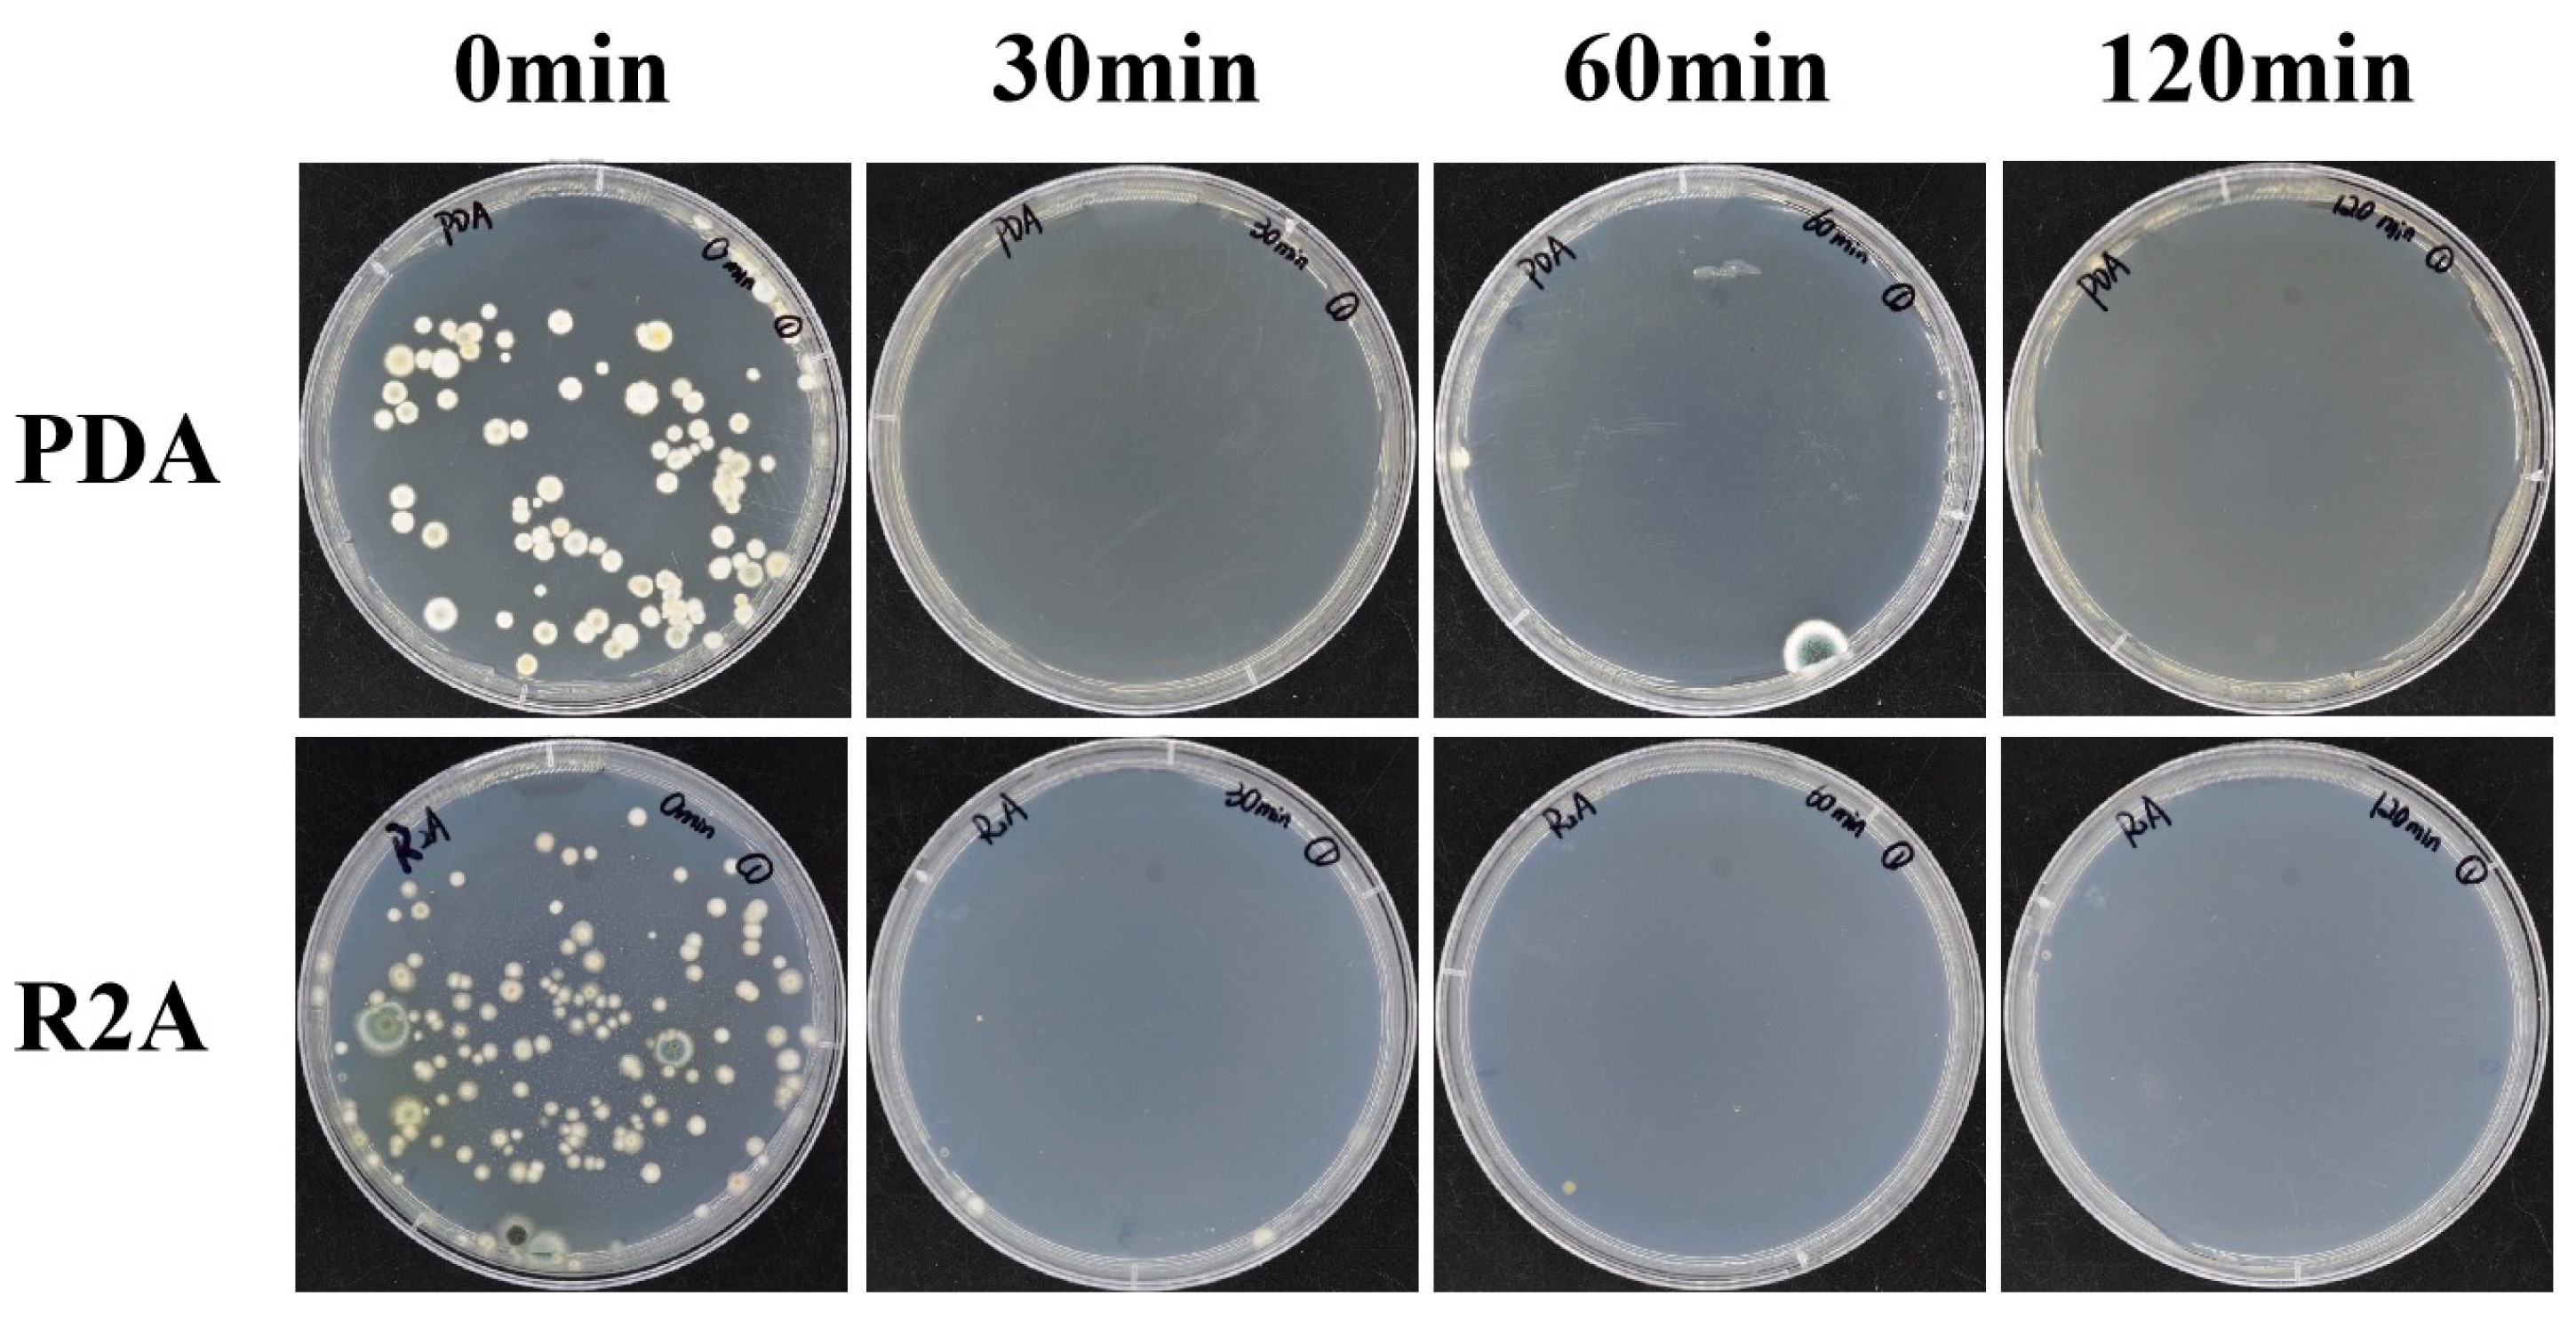
Coatings 14 00100 g012

Preliminary Study on Microbial Deterioration Control and Effectiveness Evaluation in the Neolithic Prehistoric Archaeological Site of Dadiwan, Northwest China
Abstract
1. Introduction
2. Materials and Methods
2.1. Study Site and Environmental Monitoring
2.2. Morphology of Harmful Microorganisms
2.2.1. In Situ Observation
2.2.2. Profile Characteristics of Samples
2.3. Removal Methods of Harmful Microorganisms
2.3.1. Screen of the Mechanical Removal Tools
2.3.2. Screen of Chemical Biocides in the Laboratory and In Situ
2.4. Inhibition of Ultraviolet Light (UV Light) to Harmful Microorganisms
2.4.1. Inhibition of UV Light to Culturable Microorganisms
2.4.2. Test of Microbial Inhibition by UV Light In Situ
2.5. Evaluation of Removal Effect on Harmful Microorganisms
2.5.1. Microscopic Observation
2.5.2. ATP Bioluminescence Assay
2.5.3. Color Difference Detection
3. Results and Discussion
3.1. Changes in Environmental Factors
3.2. Morphological Characteristics of Harmful Microorganisms
3.2.1. In Situ Morphology and Distribution of Harmful Microorganisms
3.2.2. Morphologic Characteristics of Residues’ Profile Structures
3.3. Evaluation of Prevention Effectiveness against Harmful Microorganisms
3.3.1. Removal Tools and Instructions
3.3.2. Effectiveness Evaluation of Mechanical Removal and Biocide Inhibition
3.4. Study of Microbial Inhibition by UV Light
3.4.1. Eliminated Effectiveness of Culturable Microorganisms under UV Light
3.4.2. Effect of UV Light on Harmful Microorganisms In Situ
3.4.3. Effectiveness Evaluation of UV Light
4. Conclusions
Author Contributions
Funding
Institutional Review Board Statement
Informed Consent Statement
Data Availability Statement
Acknowledgments
Conflicts of Interest
References
- Shan, J.X. A site museum for the preservation and display of archaeological sites. Mus. Stud. 2011, 1, 3–26. (In Chinese) [Google Scholar]
- Huang, Y.S. Study on the Protection and Utilization of Du Ling, Emperor Xuan of Han Dynasty. Master’s Thesis, Northwest University, Xi’an, China, 2019. (In Chinese). [Google Scholar]
- Zhao, Q. Context Theory Type Site Museum in Space. Master’s Thesis, Xi’an Academy of Fine Arts, Xi’an, China, 2013. (In Chinese). [Google Scholar]
- Dou, N. Research on Environmental Control of Protection and Display Facilities for Brick Archeological Site—Taking the Sunwu Tomb in Nanjing Shangfang as an Example. Master’s Thesis, Southeast University, Nanjing, China, 2019. (In Chinese). [Google Scholar]
- Wu, F.S.; Zhu, F.Q.; Wang, W.F.; Duan, Y.L.; Tian, Y.; Feng, H.Y. Review of microbial deterioration and control of Takamatsuzuka Tumulus, Japan. Sci. Conserv. Archaeol. 2019, 31, 26–35. (In Chinese) [Google Scholar] [CrossRef]
- Bastian, F.; Alabouvette, C. Lights and shadows on the conservation of a rock art cave: The case of Lascaux Cave. Int. J. Speleol. 2009, 38, 55–60. [Google Scholar] [CrossRef]
- Saiz -Jimenez, C.; Cuezva, S.; Jurado, V.; Fernandez-Cortes, A.; Porca, E.; Benavente, D.; Cañaveras, J.C.; Sanchez-Moral, S. Paleolithic art in peril: Policy and science collide at Altamira Cave. Science 2011, 334, 42–43. [Google Scholar] [CrossRef] [PubMed]
- A1lemand, L.; Bahn, P.G. Best way to protect rock art is to leave it alone. Nature 2005, 433, 800. [Google Scholar] [CrossRef]
- Kantzas, A.; Stehmeier, L.; Marentette, D.F.; Ferris, F.G.; Jha, K.N.; Maurits, F.M. A Novel Method of Sand Consolidation Through Bacteriogenic Mineral Plugging. In Proceedings of the Annual Technical Meeting, Calgary, BC, Canada, 6 June 1992; p. 46. [Google Scholar]
- Mitchell, J.K.; Santamarina, J.C. Biological considerations in geotechnical engineering. J. Geotech. Geoenviron. Eng. 2005, 131, 1222–1233. [Google Scholar] [CrossRef]
- Ettenauer, J.; Jurado, V.; Piñar, G.; Miller, A.Z.; Santner, M.; Saiz-Jimenez, C.; Sterflinger, K. Halophilic microorganisms are responsible for the rosy discoloration of saline environments in three historical buildings with mural paintings. PLoS ONE 2014, 9, e103844. [Google Scholar] [CrossRef]
- Abdel-Haliem, M.E.F.; Sakr, A.A.; Ali, M.F.; Ghaly, M.F.; Sohlenkamp, C. Characterization of Streptomyces isolates causing colour changes of mural paintings in ancient Egyptian tombs. Microbiol. Res. 2013, 168, 428–437. [Google Scholar] [CrossRef]
- Kushwaha, M.; Marwa, N.; Pandey, V.; Singh, N. Advanced Tools to Assess Microbial Diversity and Their Functions in Restoration of Degraded Ecosystems. In Microbial Services in Restoration Ecology; Elsevier: Amsterdam, The Netherlands, 2020; pp. 83–97. [Google Scholar] [CrossRef]
- Wagg, C.; Bender, S.F.; Widmer, F.; Van Der Heijden, M.G.A. Soil biodiversity and soil community composition determine ecosystem multifunctionality. Proc. Natl. Acad. Sci. USA 2014, 111, 5266–5270. [Google Scholar] [CrossRef]
- Li, J.; He, Y.; He, C.; Xiao, L.; Wang, N.; Jiang, L.M.; Chen, J.C.; Liu, K.; Chen, Q.; Gu, Y.F.; et al. Diversity and composition of microbial communities in Jinsha earthen site under different degrees of deterioration. Environ. Res. 2024, 242, 117675. [Google Scholar] [CrossRef]
- Cappitelli, F.; Cattò, C.; Villa, F. The control of cultural heritage microbial deterioration. Microorganisms 2020, 8, 1542. [Google Scholar] [CrossRef]
- Sun, M.; Zhang, F.; Huang, X.; Han, Y.Q.; Jiang, N.; Cui, B.; Guo, Q.L.; Kong, M.Y.; Song, L.; Pan, J. Analysis of microbial community in the archaeological ruins of Liangzhu City and study on protective materials. Front. Microbiol. 2020, 11, 684. [Google Scholar] [CrossRef] [PubMed]
- Wang, Y.; Huang, W.; Han, Y.; Huang, X.D.; Wang, C.; Ma, K.X.; Kong, M.Y.; Jiang, N.; Pan, J. Microbial diversity of archaeological ruins of Liangzhu City and its correlation with environmental factors. Int. Biodeterior. Biodegrad. 2022, 175, 105501. [Google Scholar] [CrossRef]
- Khalil, M.M.E.; Mekawey, A.A.I.; Alatawi, F.A. Microbial deterioration of the archaeological Nujoumi Dome (Egypt-Aswan): Identification and suggested control treatments by natural products. J. Pure Appl. Microbiol. 2022, 16, 990–1003. [Google Scholar] [CrossRef]
- Joseph, E. Microorganisms in the Deterioration and Preservation of Cultural Heritage; Springer Nature: Berlin/Heidelberg, Germany, 2021; p. 367. [Google Scholar] [CrossRef]
- Chu, W.M.; Xia, Y.; Luo, X.L.; Wang, L.Q.; Zhang, S.X. A preliminary discussion on soil site statistics and disease control in the site museum. Hum. Cult. Herit. Preserv. 2019, 1, 126–130. (In Chinese) [Google Scholar]
- Chen, R.Y. Study of floor materials in the new stone age at the site of Sadiwan, Qinan County, Gansu Province. J. Chin. Ceram. Soc. 1993, 4, 309–318. (In Chinese) [Google Scholar]
- Lang, S.D. A preliminary study of the house ruins at Dadiwan Site. Archaeol. Herit. 2002, 5, 12–17. (In Chinese) [Google Scholar]
- Lang, S.D. Discovery and preliminary study of the Dadiwan Site. Gansu Soc. Sci. 2002, 5, 136–139. (In Chinese) [Google Scholar] [CrossRef]
- Li, N.; Su, B.M.; Feng, Y.Q.; Cui, Q.; Zhang, W.Y. A disease analysis of Xixia period murals in Cave No. 88 at the Mogao Grottoes. Relics Museol. 2021, 6, 80–89. (In Chinese) [Google Scholar]
- He, D.P.; Wu, F.S.; Ma, W.X.; Gu, J.D.; Xu, R.H.; Hu, J.J.; Yue, Y.Q.; Ma, Q.; Wang, W.F.; Li, S.W. Assessment of cleaning techniques and its effectiveness for controlling biodeterioration. fungi on wall paintings of Maijishan Grottoes. Int. Biodeterior. Biodegrad. 2022, 171, 105406. [Google Scholar] [CrossRef]
- Wu, F.S.; Ma, W.X.; He, D.P.; Tian, T.; Wang, J.; Liu, Y.; Zhang, Q.; Wu, G.W.; Wang, W.F.; Feng, H.Y. The diversity of cultivable fungi on corridor murals and controlling of microbial deterioration in Xu Xianxiu’s tomb of the Northern Qi dynasty, Taiyuan. Microbiol. China 2021, 48, 2548–2560. (In Chinese) [Google Scholar] [CrossRef]
- Sanmartín, P.; Rodríguez, A.; Aguiar, U. Medium-term field evaluation of several widely used cleaning-restoration techniques applied to algal biofilm formed on a granite-built historical monument. Int. Biodeterior. Biodegrad. 2020, 147, 104870. [Google Scholar] [CrossRef]
- Pozo-antonio, J.S.; Montojo, C.; López de Silanes, M.E.; De Rosario, I.; Rivas, T. In situ evaluation by color spectrophotometry of cleaning and protective treatments in granitic Cultural Heritage. Int. Biodeterior. Biodegrad. 2017, 123, 251–261. [Google Scholar] [CrossRef]
- Bastian, F.; Alabouvette, C.; Urado, V.; Saiz-Jimenez, C. Impact of biocide treatments on the bacterial communities of the Lascaux Cave. Naturwissenschaften 2009, 96, 863–868. [Google Scholar] [CrossRef]
- Favero-longo, S.E.; Vannini, A.; Benesperi, R.; Bianchi, E.; Fačkovcová, Z.; Giordani, P.; Malaspinae, P.; Martire, L.; Matteucci, E.; Paoli, L. The application protocol impacts the effectiveness of biocides against lichens. Int. Biodeterior. Biodegrad. 2020, 155, 105105. [Google Scholar] [CrossRef]
- Wang, Y.; Wang, C.; Yang, X.Y.; Ma, K.X.; Guo, P.F.; Sun, Q.R.; Jia, S.L.; Pan, J. Analysis and control of fungal deterioration on the surface of pottery figurines unearthed from the tombs of the Western Han Dynasty. Front. Microbiol. 2022, 13, 956774. [Google Scholar] [CrossRef]
- Liu, Z.; Fu, T.; Hu, C.; Shen, D.W.; Macchioni, N.; Sozzi, L.; Chen, Y.; Liu, J.; Tian, X.L.; Ge, Q.Y.; et al. Microbial community analysis and biodeterioration of waterlogged archaeological wood from the Nanhai No. 1 shipwreck during storage. Sci. Rep. 2018, 8, 7170. [Google Scholar] [CrossRef]
- Wu, F.S.; Su, B.M.; He, D.P.; Gu, H.B.; Xu, R.H.; Wang, W.F. Identification of the dominant fungal groups in Tanjiapo ruins museum of Changsha Tongguan kiln-sites. Sci. Conserv. Archaeol. 2014, 26, 47–53. (In Chinese) [Google Scholar] [CrossRef]
- Ding, J.R.; Zhang, L.; Guo, H.Y.; Zhang, X.Y.; Chen, C. Reinvestigation of fungal species and reevaluation of the antifungal effect of the fungicide used for the Zhidanyuan Sluice Site of the Yuan Dynasty. Sci. Conserv. Archaeol. 2018, 30, 99–103. (In Chinese) [Google Scholar] [CrossRef]
- Zhang, Z.J. Study on Cultural Relics Protection of Terracotta Warriors and Horses in Qin Shihuang Mausoleum; Shaanxi People’s Education Press: Xi’an, China, 1998; ISBN 9787541971785. (In Chinese) [Google Scholar]
- Zhang, X.Q.; Zhang, Z.J.; Zhang, X.R. Investigation and harm of fungi flora in Qin Terra-cotta. Cult. Mus. 1999, 1, 76–80+83. (In Chinese) [Google Scholar]
- Jia, W.T. The Physical and Chemical Relationship between Indoor Air Quality and Atmospheric Corrosion in Site Museum. Master’s Thesis, The University of Chinese Academy of Sciences, Beijing, China, 2015. (In Chinese). [Google Scholar]
- Yang, Q.Y.; Li, C.W. Research on the Impact of Drying and Wetting Cycle of Capillary Water on Weathering of Soil Sites. Chin. J. Undergr. Space Eng. 2012, 3, 517–525. (In Chinese) [Google Scholar]
- Lu, J.S. The big cultural sites in China: Protection cases, existing problems and suggestions. Fudan J. (Soc. Sci. Ed.) 2005, 6, 130–136. (In Chinese) [Google Scholar] [CrossRef]
- Mascalchi, M.; Orsini, C.; Pinna, D.; Salvadori, B.; Siano, S.; Riminesi, C. Assessment of different methods for the removal of biofilms and lichens on gravestones of the English Cemetery in Florence. Int. Biodeterior. Biodegrad. 2020, 154, 105041. [Google Scholar] [CrossRef]
- Schröder, V.; Carutiu, D.T.; Honcea, A.; Ion, R.M. Microscopical methods for the in situ investigation of biodegradation on Cultural Heritage. In Advanced Methods and New Materials for Cultural Heritage Preservation; Turcanu-Carutiu, D., Ion, R.M., Eds.; IntechOpen: London, UK, 2019; p. 79. [Google Scholar]
- Savković, Ž.; Unković, N.; Stupar, M.; Franković, M.; Jovanović, M.; Erić, S.; Šarić, K.; Stanković, S.; Dimkić, I.; Vukojević, J.; et al. Diversity and biodeteriorative potential of fungal dwellers on ancient stone stela. Int. Biodeterior. Biodegrad. 2016, 115, 212–223. [Google Scholar] [CrossRef]
- Unkovic, N.; Grbic, M.L.; Stupar, M.; Jelikić, A.; Stanojević, D.; Vukojević, J. Fungal-induced deterioration of mural paintings: In situ and mock-model microscopy analyses. Microsc. Microanal. 2016, 22, 410–421. [Google Scholar] [CrossRef]
- Dong, M.; Hu, H.; Guo, Q.; Gong, X.N.; Azzam, R.; Kong, M.Y. Correlation of environmental parameters and the water saturation induced deterioration of earthen archaeological sites: The case of world heritage Liangzhu city, China. Heritage 2021, 4, 387–400. [Google Scholar] [CrossRef]
- Lercari, N. Monitoring earthen archaeological heritage using multi-temporal terrestrial laser scanning and surface change detection. J. Cult. Herit. 2019, 39, 152–165. [Google Scholar] [CrossRef]
- Pan, C.; Chen, K.; Chen, D.; Xi, S.; Geng, J.; Zhu, D. Research progress on in-situ protection status and technology of earthen sites in moisty environment. Constr. Build. Mater. 2020, 253, 119219. [Google Scholar] [CrossRef]
- Su, C.; Zhang, Q.; Wang, L.; Cai, Y.W. Research application of ATP bioluminescence method in relation to the total number of bacteria. City Town Water Supply 2023, 2, 55–58. (In Chinese) [Google Scholar] [CrossRef]
- Pan, X.X.; Ge, Q.Y.; Pan, J. Damage to ancient mural paintings and petroglyphs caused by Pseudonocardia sp.-A review. Acta Microbiol. Sin. 2015, 55, 813–818. (In Chinese) [Google Scholar] [CrossRef]
- Tan, D.; Ma, Z.; Tan, B.W.; Chen, M.J.; Liu, J.L.; Liu, H.C.; Tang, H. Detection and application of cultural relic mildew based on ATP bioluminescence method. Sci. Conserv. Archaeol. 2023, 35, 168846. (In Chinese) [Google Scholar] [CrossRef]
- Ge, Q.Y.; Pan, X.X.; Li, Q.; Pan, J.; Guo, H. Application of ATP-bioluminescence method for the evaluation of biocides used for cultural heritage conservation. Sci. Conserv. Archaeol. 2014, 26, 39–46. (In Chinese) [Google Scholar] [CrossRef]
- Unkovic, N.; Ljaljevic Grbic, M.; Stupar, M.; Vukojević, J.; Subakov-Simić, G.; Jelikić, A.; Stanojević, D. ATP bioluminescence method: A tool for rapid screening of organic and microbial contaminants on deteriorated mural paintings. Nat. Prod. Res. 2019, 33, 1061–1069. [Google Scholar] [CrossRef]
- Szulc, J.; Komar, M.; Kata, I.; Szafran, K.; Gutarowska, B. Novel Method for Assessing the Protection Lifetime of Building Coatings against Fungi. Coatings 2023, 13, 2026. [Google Scholar] [CrossRef]
- Wu, F.S.; Li, J.; Li, R.X.; He, D.P. Advances of biocides and antimicrobial nano-materials applied in cultural heritage conversation. Sci. Conserv. Archaeol. 2023, 35, 115–127. (In Chinese) [Google Scholar] [CrossRef]
- Jia, Y.; Yin, L.Y.; Zhang, F.Y.; Wang, M.; Sun, M.L.; Hu, C.T.; Liu, Z.J.; Chen, Y.; Liu, J.; Pan, J. Fungal community analysis and biodeterioration of waterlogged wooden lacquerware from the Nanhai No. 1 shipwreck. Appl. Sci. 2020, 10, 3797. [Google Scholar] [CrossRef]
- Wang, L.; Wang, Y.; Yang, X.Y.; Wang, C.; Li, C.H.; Cui, S.K.; Pan, J. Analysis and prevention of fungal deterioration on the surface and in the storage environment of bricks unearthed from the mausoleum of Dingtao King. Microbiol. China 2022, 49, 2515–2526. (In Chinese) [Google Scholar] [CrossRef]
- Yue, J.W.; Chen, Y.; Zhao, L.M.; Zhang, B.X.; Kong, Q.M.; Gu, L.H.; Lu, H.F. Strength characteristics and mechanism of modified imitation ruins soil of Qicheng site with glutinous rice slurry. J. Civ. Environ. Eng. 2022, 44, 195–204. (In Chinese) [Google Scholar] [CrossRef]
- Zhou, H.; Qian, W.; Zhou, W.R. Application of color measurement in cultural relics and archaeology. Sci. Conserv. Archaeol. 2021, 33, 125–132. (In Chinese) [Google Scholar] [CrossRef]
- Prieto, B.; Vázquez-Nion, D.; Fuentes, E.; Durán-Román, A.G. Response of subaerial biofilms growing on stone-built cultural heritage to changing water regime and CO2 conditions. Int. Biodeterior. Biodegrad. 2020, 148, 104882. [Google Scholar] [CrossRef]
- Sanmartín, P.; Chorro, E.; Vázquez-Nion, D.; Martínez-Verdú, F.M.; Prieto, B. Conversion of a digital camera into a non-contact colorimeter for use in stone cultural heritage: The application case to Spanish granites. Measurement 2014, 56, 194–202. [Google Scholar] [CrossRef]
- Ion, R.M.; Lancu, L.; Grigorescu, R.M.; Tincu, S.; Vasilievici, G.; Ion, N.; Bucurica, I.A.; Teodorescu, S.; Dulama, I.D.; Stirbescu, R.M.; et al. Archaeometric investigations on ceramic materials from Hunedoara—The Court Area. J. Sci. Arts 2018, 2, 471–480. [Google Scholar]
- Germinario, C.; Cultrone, G.; De Bonis, A.; Izzo, F.; Langella, A.; Mercurio, M.; Morra, V.; Santoriello, A.; Siano, S.; Grifa, C. The combined use of spectroscopic techniques for the characterization of Late Roman common wares from Benevento (Italy). Measurement 2018, 114, 515–525. [Google Scholar] [CrossRef]
- Imperi, F.; Caneva, G.; Cancellieri, L.; Ricci, M.A.; Sodo, A.; Visca, P. The bacterial etiology of rosy discoloration of ancient wall paintings. Environ. Microbiol. 2007, 9, 2894–2902. [Google Scholar] [CrossRef]
- Piñar, G.; Ettenauer, J.; Sterflinger, K. “La vie en rose”: A review of the rosy discoloration of subsurface monuments. In The Conservation of Subterranean Cultural Heritage; Saiz-Jimenez, C., Ed.; CRC Press/Balkema: Leiden, The Netherlands, 2014; pp. 113–124. [Google Scholar]
- Tescari, M.; Visca, P.; Frangipani, E.; Bartoli, F.; Rainer, L.; Caneva, G. Celebrating centuries: Pink-pigmented bacteria from rosy patinas in the House of Bicentenary (Herculaneum, Italy). J. Cult. Herit. 2018, 34, 43–52. [Google Scholar] [CrossRef]
- Rosado, T.; Gil, M.; Mirão, J.; Candeias, A.; Caldeira, A.T. Darkening on lead-based pigments: Microbiological contribution. Color Res. Appl. 2016, 41, 294–295. [Google Scholar] [CrossRef]
- Pathare, P.B.; Opara, U.L.; Al-Said, F.A.J. Colour measurement and analysis in fresh and processed foods: A review. Food Bioprocess Technol. 2013, 6, 36–60. [Google Scholar] [CrossRef]
- Rodrigues, J.D.; Grossi, A. Indicators and ratings for the compatibility assessment of conservation actions. J. Cult. Herit. 2007, 8, 32–43. [Google Scholar] [CrossRef]
- Huang, S.P.; Li, Y.H.; Zhang, H. The Opinion of Chrominance and Ventilation Property Researches in the Protection of the Earthen Sites. J. Xianyang Norm. Univ. 2008, 2, 40–42. (In Chinese) [Google Scholar] [CrossRef]
- Camerini, R.; Chelazzi, D.; Giorgi, R.; Baglioni, P. Hybrid nano-composites for the consolidation of earthen masonry. J. Colloid Interface Sci. 2019, 539, 504–515. [Google Scholar] [CrossRef]
- Zhang, J.F. Discussion on Color Difference by Chemical Consolidation on Earthen Sites. China Cult. Herit. Sci. Res. 2016, 4, 51–57. (In Chinese) [Google Scholar] [CrossRef]
- President of ICOMOS China. Principles for the Conservation of Heritage Sites in China (Revised 2015); Cultural Relics Press: Beijing, China, 2015; Chapter 2; pp. 10–14. ISBN 978-7-5010-4400-9. (In Chinese) [Google Scholar]
- Reed, N.G. The history of ultraviolet germicidal irradiation for air disinfection. Public Health Rep. 2010, 125, 15–27. [Google Scholar] [CrossRef]
- Miller, S.L.; Linnes, J.; Luongo, J. Ultraviolet germicidal irradiation: Future directions for air disinfection and building applications. Photochem. Photobiol. 2013, 89, 777–781. [Google Scholar] [CrossRef]
- Bergman, R.S. Germicidal UV sources and systems. Photochem. Photobiol. 2021, 97, 466–470. [Google Scholar] [CrossRef]
- Nakazawa, F.; Goto-Azuma, K. Ultraviolet germicidal irradiation of melted snow and ice samples: Inactivation of microorganisms and effects on insoluble microparticles. J. Glaciol. 2022, 68, 166–173. [Google Scholar] [CrossRef]
- Kraková, L.; Šoltys, K.; Otlewska, A.; Pietrzak, K.; Purkrtová, S.; Puškárová, A.; Bučková, M.; Szemes, T.; Budiš, J.; Demnerová, K.; et al. Comparison of methods for identification. of microbial communities in book collections: Culture-dependent (sequencing and MALDI-TOF MS) and culture-independent (Illumina MiSeq). Int. Biodeterior. Biodegrad. 2018, 131, 51–59. [Google Scholar] [CrossRef]
- Cutler, T.D.; Zimmerman, J.J. Ultraviolet irradiation and the mechanisms underlying its inactivation of infectious agents. Anim. Health Res. Rev. 2011, 12, 15–23. [Google Scholar] [CrossRef]
- Zhou, S.P.; Chen, X.P.; Gao, H.; Cai, W. Methods of Microbiological Examination for Air in Public Places—Determination of Aerobic Bacterial Count (GB/T 18204.1-2000); State Administration of Quality and Technical Supervision: Beijing, China, 2000. (In Chinese) [Google Scholar]
- Katara, G.; Hemvani, N.; Chitnis, S.; Chitnis, V.; Chitnis, D. Surface disinfection by exposure to germicidal UV light. Indian J. Med. Microbiol. 2008, 26, 241–242. [Google Scholar] [CrossRef]
- Wang, L.; Xu, Y.; Tan, Z.; Chen, Y.Y. Experimental observation of new standard UV germicidal lamp on germicidal efficacy of microbiology. Chin. J. Disinfect. 2008, 25, 253–255. (In Chinese) [Google Scholar] [CrossRef]
- Zhang, F.Y.; Kuang, F. Experimental observation of factors influencing bactericidal efficacy of ultraviolet lamp. Chin. J. Disinfect. 2005, 22, 318–319. (In Chinese) [Google Scholar] [CrossRef]
- Li, L.W.; Chen, Y.Y.; Li, K.L.; Chen, J.P.; Zhang, Z.G.; Yang, Y. Experimental Measurement and Analysis of the Irradiance of Different Types of Ultraviolet Germicidal Lamp. China Light Light. 2018, 11, 18–22. (In Chinese) [Google Scholar] [CrossRef]
- Leuschner, W.; Salie, F. Characterizing ultraviolet germicidal irradiance luminaires. Photochem. Photobiol. 2013, 89, 811–815. [Google Scholar] [CrossRef] [PubMed]
- Kowalski, W. Ultraviolet Germicidal Irradiation Handbook: UVGI for Air and Surface Disinfection; Springer: New York, NY, USA, 2010; pp. 190, 191, 239, 241. [Google Scholar]
- Mcdevittj, J.; Rudnick, S.N.; Radonovich, L.J. Aerosol susceptibility of influenza virus to UV-C light. Appl. Environ. Microbiol. 2012, 78, 1666–1669. [Google Scholar] [CrossRef] [PubMed]
- Li, J.X.; Gao, L. Aspects Review of Influencing UVGI in Air Stream Disinfection. Refrig. Air Cond. 2006, 3, 86–89. (In Chinese) [Google Scholar]
- Menetrez, M.Y.; Foarde, K.K.; Dean, T.R.; Betancourt, D.A. The effectiveness of UV irradiation on vegetative bacteria and fungi surface contamination. Chem. Eng. J. 2010, 157, 443–450. [Google Scholar] [CrossRef]
- Neu, D.T.; Mead, K.R.; McClelland, T.L.; Lindsley, W.G.; Martin, S.B.; Heil, G.J.; See, M.; Feng, H.A. Surface Dosimetry of Ultraviolet Germicidal Irradiation Using a Colorimetric Technique. Ann. Work Expo. Health 2021, 65, 605–611. [Google Scholar] [CrossRef]

| Evaluation Methods | Coarse Surface | Smooth Surface | Site Ground | Cement Wall |
|---|---|---|---|---|
| Eliminated ratio (%) | 24.30 ± 13.14 | 38.00 ± 17.29 | 37.70 ± 15.08 | 58.86 ± 15.19 |
| Color difference value (∆E*ab) | 3.64 ± 1.83 | 2.80 ± 1.47 | 2.86 ± 1.55 | 1.93 ± 1.40 |
Disclaimer/Publisher’s Note: The statements, opinions and data contained in all publications are solely those of the individual author(s) and contributor(s) and not of MDPI and/or the editor(s). MDPI and/or the editor(s) disclaim responsibility for any injury to people or property resulting from any ideas, methods, instructions or products referred to in the content. |
© 2024 by the authors. Licensee MDPI, Basel, Switzerland. This article is an open access article distributed under the terms and conditions of the Creative Commons Attribution (CC BY) license (https://creativecommons.org/licenses/by/4.0/).
Share and Cite
Xu, R.; Chen, Y.; He, D.; Zhang, G.; Luo, Q.; Zhan, H.; Wu, F. Preliminary Study on Microbial Deterioration Control and Effectiveness Evaluation in the Neolithic Prehistoric Archaeological Site of Dadiwan, Northwest China. Coatings 2024, 14, 100. https://doi.org/10.3390/coatings14010100
Xu R, Chen Y, He D, Zhang G, Luo Q, Zhan H, Wu F. Preliminary Study on Microbial Deterioration Control and Effectiveness Evaluation in the Neolithic Prehistoric Archaeological Site of Dadiwan, Northwest China. Coatings. 2024; 14(1):100. https://doi.org/10.3390/coatings14010100
Chicago/Turabian StyleXu, Ruihong, Yuxin Chen, Dongpeng He, Guobin Zhang, Qiang Luo, Hongtao Zhan, and Fasi Wu. 2024. "Preliminary Study on Microbial Deterioration Control and Effectiveness Evaluation in the Neolithic Prehistoric Archaeological Site of Dadiwan, Northwest China" Coatings 14, no. 1: 100. https://doi.org/10.3390/coatings14010100
APA StyleXu, R., Chen, Y., He, D., Zhang, G., Luo, Q., Zhan, H., & Wu, F. (2024). Preliminary Study on Microbial Deterioration Control and Effectiveness Evaluation in the Neolithic Prehistoric Archaeological Site of Dadiwan, Northwest China. Coatings, 14(1), 100. https://doi.org/10.3390/coatings14010100
